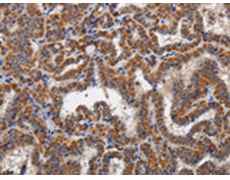
一抗

|
Background: |
Kallikreins are a subgroup of serine proteases having diverse physiological functions. Growing evidence suggests that many kallikreins are implicated in carcinogenesis and some have potential as novel cancer and other disease biomarkers. This gene is one of the fifteen kallikrein subfamily members located in a cluster on chromosome 19. The encoded enzyme is regulated by steroid hormones. In tissue culture, the enzyme has been found to generate amyloidogenic fragments from the amyloid precursor protein, suggesting a potential for involvement in Alzheimer's disease. Multiple alternatively spliced transcript variants that encode different isoforms have been identified for this gene. |
|
Applications: |
ELISA, IHC |
|
Name of antibody: |
KLK6 |
|
Immunogen: |
Fusion protein of human KLK6 |
|
Full name: |
kallikrein-related peptidase 6 |
|
Synonyms: |
hK6; Bssp; Klk7; SP59; PRSS9; PRSS18 |
|
SwissProt: |
Q92876 |
|
ELISA Recommended dilution: |
2000-10000 |
|
IHC positive control: |
Human thyroid cancer and human brain |
|
IHC Recommend dilution: |
100-300 |

 購物車
購物車 幫助
幫助
 021-54845833/15800441009
021-54845833/15800441009